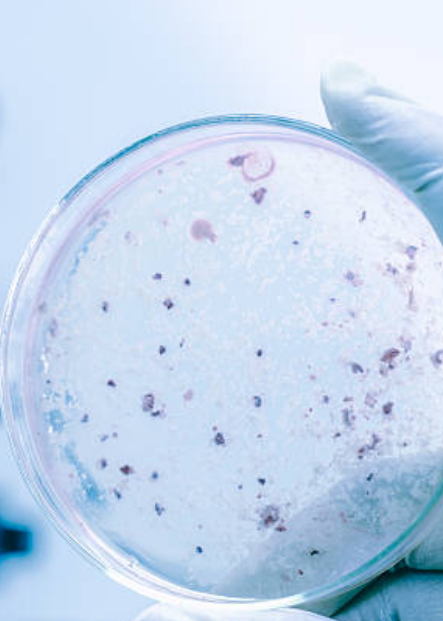

Lejyonella Yönetmeliği:
Su Tesisatlarında Sağlığımızı Koruma Kılavuzu
Lejyonella, su sistemlerinde üreyen tehlikeli bir bakteri türüdür ve insan sağlığına ciddi tehditler oluşturabilir. Lejyonella bakterisi, su sistemlerinde büyüyebilir ve havalandırma sistemlerinden yayılabilir. Bu nedenle, Lejyonella’nın kontrol altına alınması için Lejyonella yönetmeliği, su tesisatlarında sağlığımızı korumak amacıyla büyük önem taşır.
Lejyonella Nedir?
Lejyonella, özellikle sıcak su sistemlerinde ve su tesisatlarında bulunan bir bakteri türüdür. Bu bakteri sıcak su tankları, duş başlıkları, musluklar ve soğutma kulelerinde yaşayabilir. Lejyonella enfeksiyonları, su buharı veya su damlacıkları yoluyla solunduğunda ciddi akciğer hastalıklarına neden olabilir.
Lejyonella Yönetmeliği ve Su Tesisatlarında Sağlık
Lejyonella’nın kontrol altına alınması, Lejyonella yönetmeliği ile düzenlenir. Bu yönetmelik, su sistemlerinde Lejyonella riskini değerlendirmenin ve azaltmanın yollarını açıklar. İşte Lejyonella yönetmeliğine uygun olarak alınması gereken bazı önlemler:
Risk Değerlendirmesi:
Su tesisatlarının potansiyel Lejyonella kaynaklarını belirlemek ve riski değerlendirmek için düzenli olarak analizler yapılmalıdır.
Sıcak Su Sistemlerinin Kontrolü: Sıcak su tankları ve şofbenler, belirli sıcaklık ve sirkülasyon koşullarında tutulmalıdır. Bu, Lejyonella’nın üremesini engeller.
Su Tesisatlarının Bakımı:
Su tesisatları düzenli olarak temizlenmeli ve dezenfekte edilmelidir.
Personel Eğitimi:
Personel, Lejyonella enfeksiyonlarını önleme konusunda eğitilmelidir.
Havalandırma Sistemleri:
Havalandırma sistemlerinin bakımı ve temizliği, Lejyonella yayılmasını önlemek için önemlidir.
Sonuç
Lejyonella yönetmeliği, su tesisatlarında Lejyonella’nın kontrol altına alınmasına yardımcı olur ve insan sağlığını korur. Su tesisatlarının düzenli olarak kontrol edilmesi ve bakımının yapılması, Lejyonella enfeksiyonlarını önlemede kritik bir rol oynar. Bu nedenle, su sistemlerini yönetenlerin Lejyonella yönetmeliğine uygun hareket etmeleri önemlidir.
Unutmayın ki Lejyonella konusu ciddi bir sağlık riski taşır, bu nedenle bu yönetmeliğe uymak, toplumun sağlığını korumak için büyük bir adımdır.

